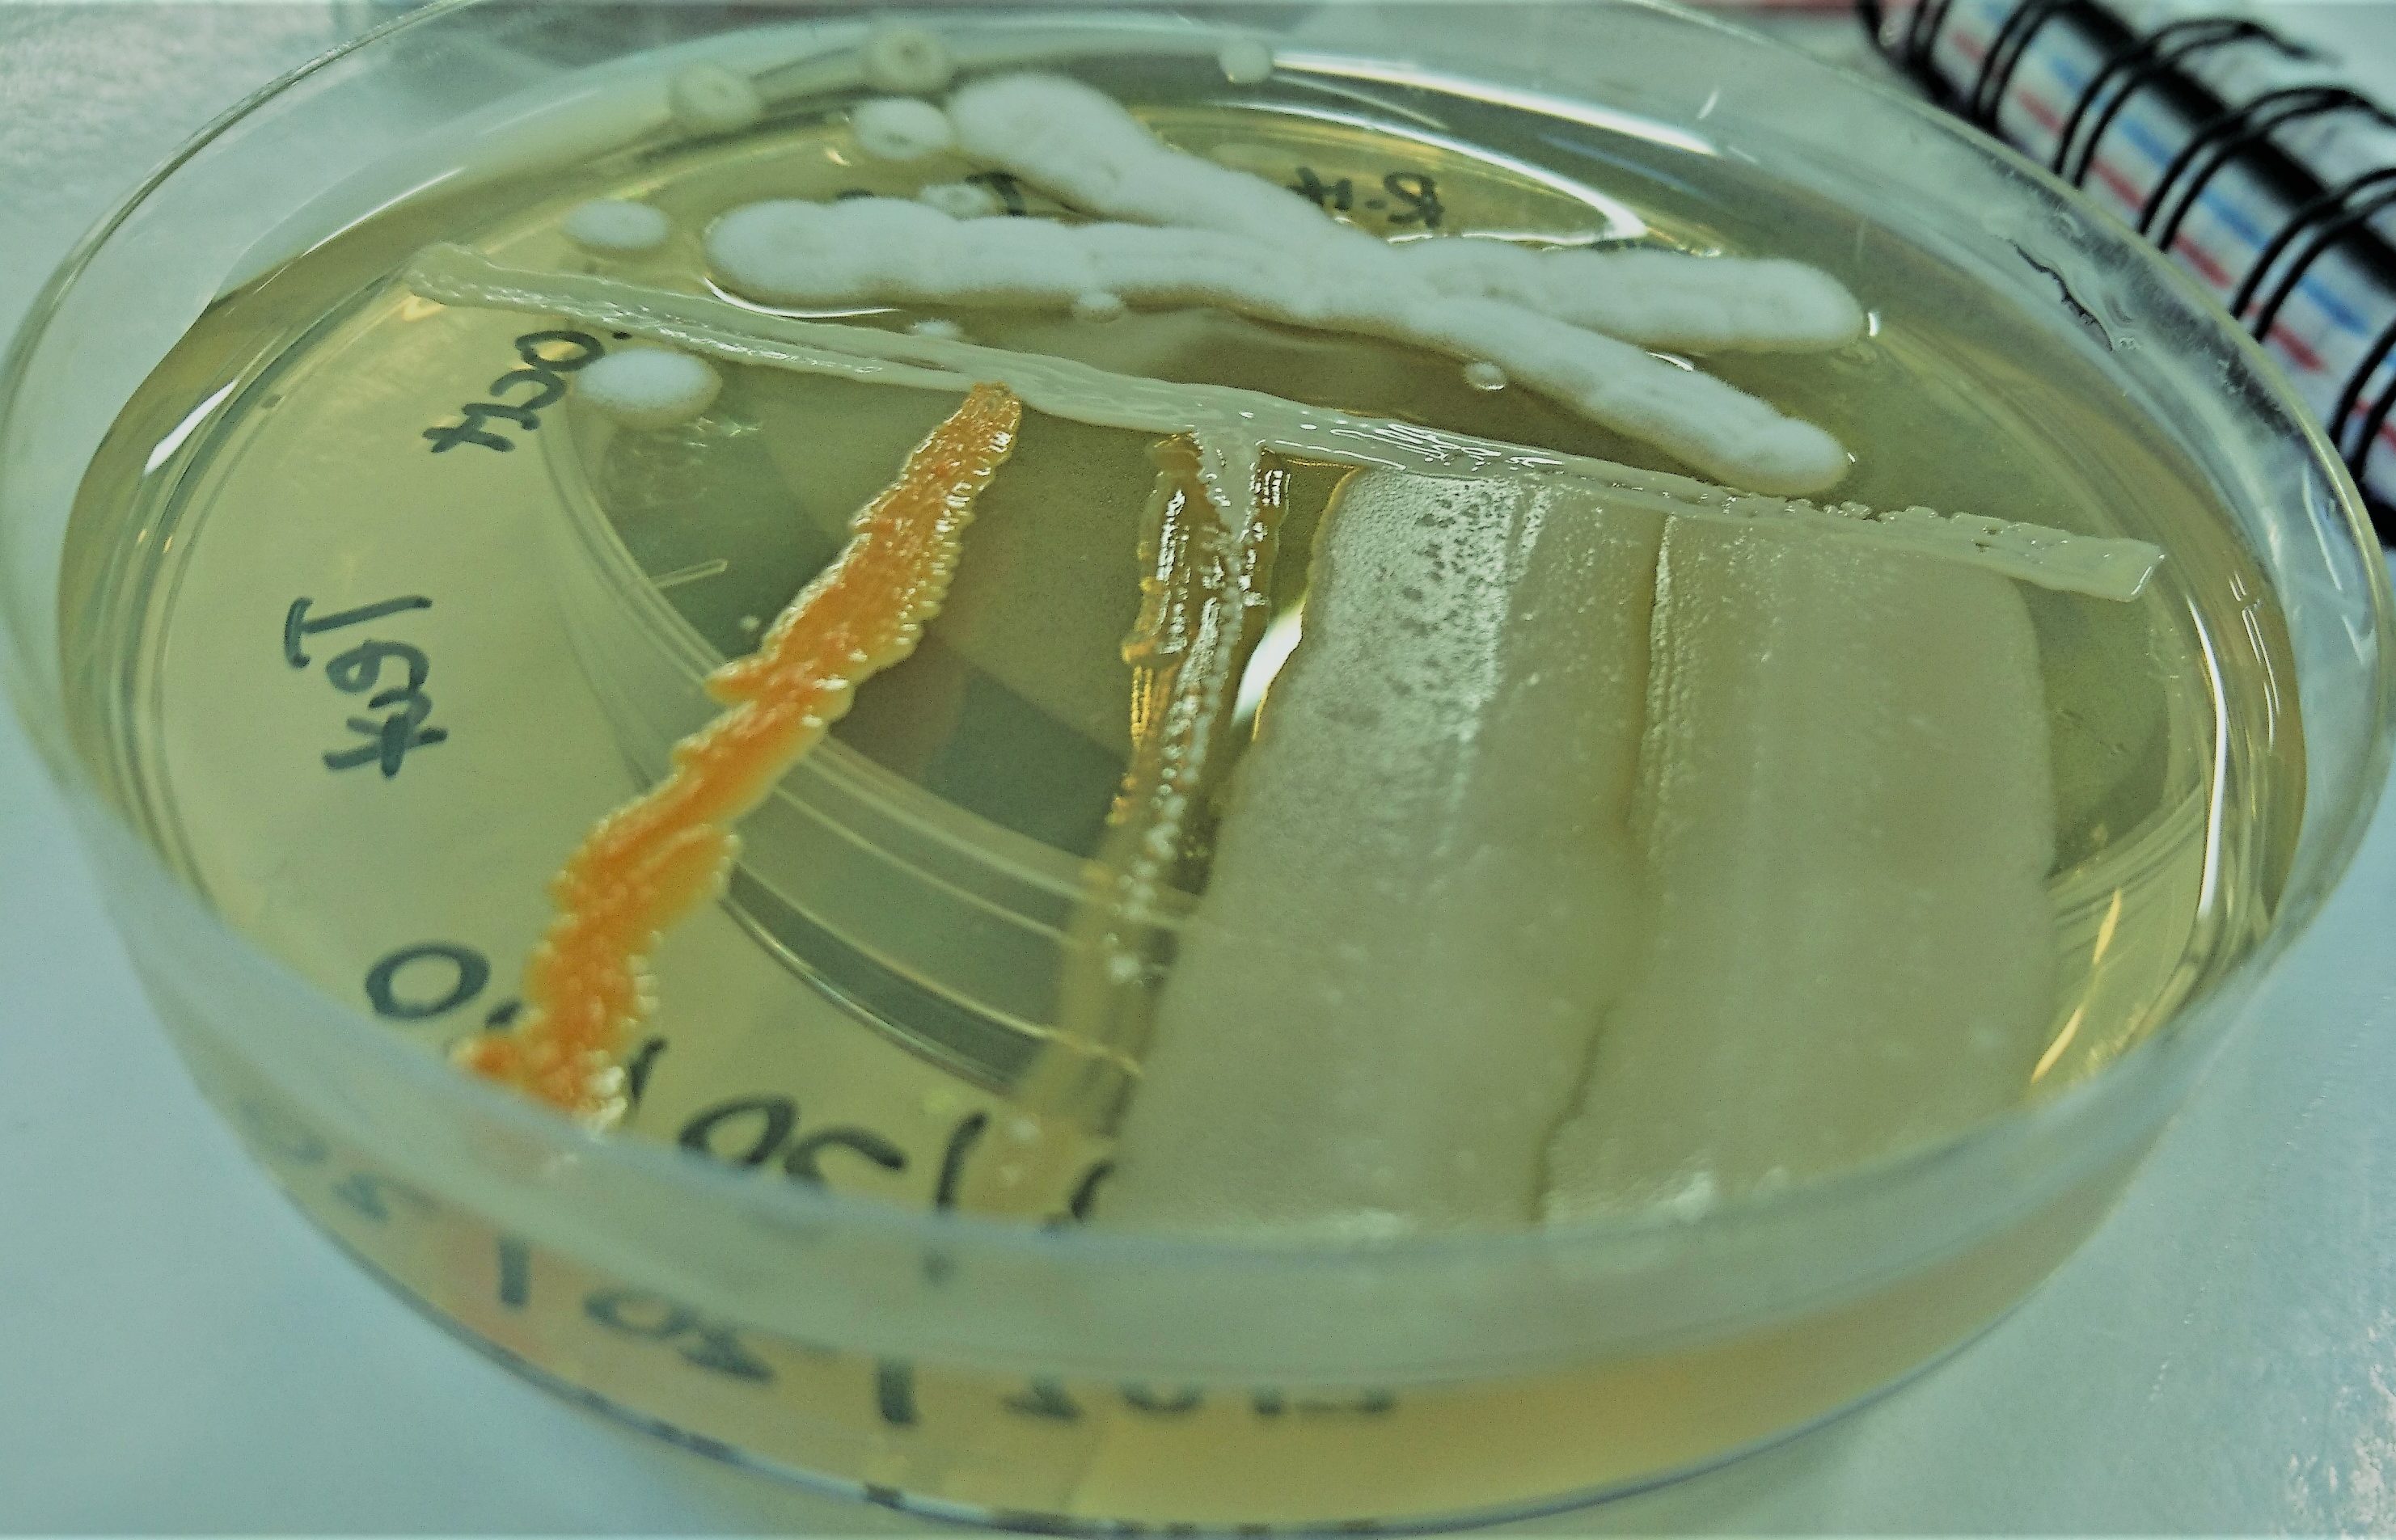
sghilazghi

Welcome to My New Blogging Blog
Unusual measures for unusual pathogen
Last year of this time, it was unusual think or predict about what is happening today and it would be unusual if someone has predicted, it would trigger many questions. We are experiencing unusual things in our day-to-day activities. The only thing we are more concerned and been the headlines of many news outlets is,…
covid-19 update
The name Corona virus given due to its appearance derived from a Latin word (Coronam) meaning crown. Corona virus was first identified in 1960’s was isolated from an adult with respiratory tract infection (common cold) (Kahn & McIntosh, 2005). It belongs to the family coronaviridae and subfamily orthocoronavirinae. Most of the Seven known corona viruses…
Follow My Blog
Get new content delivered directly to your inbox.